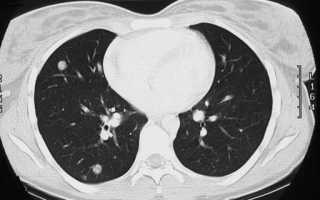
Множественные метастазы в легких

Метастазы в легких – результат распространения злокачественной опухоли (первичного очага) легочной и любой другой локализации. Метастазы характеризуют наступление терминальной стадии онкологической болезни, неблагоприятный прогноз на жизнь. Химио- или лучевая терапия, а также хирургия малоэффективны, часто больные нуждаются лишь в паллиативной терапии. Вторичные очаги (метастазы) чаще локализуются в правом легком, нарушают функцию дыхания, рано или поздно приводят к дыхательной и сердечной недостаточности.
Что такое метастазы
Метастазы (от греч. “перемещение”) – отдаленные вторичные очаги злокачественной опухоли, которые провоцируют новые раковые опухоли. Почти у 50% больных с раковой опухолью любой локализации обнаруживают метастазы в легких, что обусловлено путем распространения. Первичный очаг может находиться в кровеносной или лимфатической системе, органах ЖКТ, почках, печени и даже в органах мочеполовых путей, репродуктивной системы.
Структура легочных метастаз обычно совпадает с морфологией и гистологией первичного очага, представляет собой узел, который тянется от первопричинного очага тонкой нитью. На рентгене метастазы легких можно увидеть особенности патологического процесса – из центральной опухоли тянутся тонкие сплетения, которые крепятся во внутренние органы и ткани узловым фрагментом. Рентгенологическая картина болезни графически напоминает рака, который расправляет щупальца по ходу своего движения.
Особенности и пути распространения
Распространенность метастаз в легочных структурах обусловлена обилием кровеносных и лимфатических сосудов, поэтому атипичные клетки быстро распространяются с током лимфы и крови, достигая тканей легких. В связи с этим выделяют гематогенный и лимфогенный путь распространения. Также вероятно имплантационное метастазирование, когда мутация клеток возникает при их соприкосновением с плеврой, тканью легких.
Классификация метастазов в легких
Классификация метастаз определяет множественные клинические критерии, которые помогают составить тактику лечения и прогноз, заключается в рассмотрении следующих аспектов.
- односторонние – наблюдается поражение только одной стороны легкого (левого или правого);
- двусторонние – метастатический процесс охватывает сразу всю структуру легких.
Метастазы в легких классифицируются по численности:
- солитарные – единичные очаги, не более 2-8;
- множественные – более 8 вторичных очагов.
При множественных метастазах в легких можно говорить о неэффективности хирургического лечения, больные нуждаются в обезболивании и паллиативном наблюдении.
Метастазирование имеет несколько основных типов:
- очаговые – менее агрессивное течение, распространение происходит гематогенным путем, при незначительном распространении можно надеяться на благоприятный прогноз;
- инфильтративные – атипичные клетки распространяется по альвеолярному эпителию, на рентгене выглядят как сетчатое затемнение, переносятся, преимущественно, лимфогенным путем, повышается риск саркомы, меланомы;
- смешанные метастазы – по признакам объединяют инфильтративные и очаговые типы метастазирования.
Благоприятный прогноз по очаговым метастазам определяется доступностью хирургических методов, отсутствием выраженных признаков дыхательной и сердечно-сосудистой недостаточности.
Существует лимфогенный (с током лимфы) и гематогенный (с током крови) путь распространения метастазов. Классификация по способу распространения носит условный характер, достоверно определить способ никогда не удается, а полученная информация никак не влияет на тактику лечения.
Существует классификация и по эффективности лечебного воздействия: чувствительные к химио- или лучевой терапии (хориокарциномы, рак яичников, остеосаркомы), малочувствительные (метастазы от немелкоклеточного рака легкого, грудных желез), а также устойчивые к химиотерапии (меланомы, рак матки, эндометрия, толстой кишки, рак почки).
Определение пути и характера метастазов можно по результатам компьютерной томографии, благодаря исследованию, определяют первичный очаг злокачественной опухоли. Обычно метастазы в легких – это рак 4 стадии.
Клинические проявления
Ранние признаки метастазирования характеризуются периодическими признаками общей интоксикации, рецидивирующими простудными заболеваниями. По мере развития или распространения патологического процесса присоединяются следующие признаки метастаз в легких:
- одышка, затрудненное дыхание вне зависимости от физической нагрузки;
- болезненность, скованность в грудине;
- отечность в верхней части туловища из-за нарушения тока крови, сдавления основных крупных сосудов;
- кашель с мокротой, сгустками крови.
Сначала симптомы могут отмечаться только при нагрузках, а после беспокоить больного в состоянии покоя. Эти же признаки характерны не только для метастаз легочной локализации, но и рака легких. Среди дополнительных признаков выделяют стойкий субфебрилитет, который принимают за симптомы простудных заболеваний и респираторных инфекций.
При единичных очагах признаки метастазирующего рака могут отсутствовать, нередко они обнаруживаются случайно при инструментальном исследовании по поводу других заболеваний. Легочная площадь в анатомии огромна, поэтому узел менее 2 см вряд ли вызовет нарушение газообмена и затруднит вентиляцию воздухоносных путей. Только множественные очаги способны ухудшить патологический процесс, вызвать постоянные симптоматические проявления.
При инфильтративных метастазах ухудшение самочувствия наступает несколько быстрее, так как к патологическому процессу присоединяется инфицирование тканей, состояние осложняется пневмонией. Антибактериальная терапия носит временный характер, воспаление рецидивирует.
Одним из ключевых симптомов метастаз в легких легочной ткани является кашель. Спастический сухой кашель имеет некоторые особенности:
- сухой кашель становится надрывным, регулярным, возникает, преимущественно, ночью;
- после сухой кашель становится продуктивным, мокрота содержит примеси крови;
- наблюдается сужение бронхиального просвета, в мокроте присутствует гной.
Если раковые метастазы прорастают в плевральную ткань, кашель становится постоянным, невыносимым, каждый приступ сопровождается сильной болью за грудиной. По мере роста опухоли нарушается воздухообмен в легких, нарастает легочная, а после и сердечно-сосудистая недостаточность.
Диагностика
Метастазы в легких сложно поддаются терапии, поэтому уповать на эффективность лечебных мероприятий можно лишь при своевременной диагностике. При появлении необъяснимых болей в груди следует обратиться к терапевту и при отсутствии признаков респираторных инфекций требуется консультация врача-онколога. Основными методами диагностики является комплекс инструментальных исследований:
- магнитно-резонансная томография – метод точно определяет количество и размеры новообразований, определяются даже узлы менее 0,3 мм;
- узи – дополнительная мера диагностики, позволяющая выявить некоторые структурные изменения в легочной ткани;
- компьютерная томография – современный и доступный метод определения вторичных раковых очагов, расположенных глубоко в тканях плевры;
- рентген – распространенный метод исследования, который может определить лишь крупные раковые вторичные опухоли.
Высокую информативность, наряду с мрт-исследованием, имеет биопсия – гистологическое исследование измененных тканей. Вспомогательными методами диагностики для дифференциации диагноза имеют лабораторные исследования (анализ мокроты, крови, мочи, кала).
Методы лечения
Лечение определяется стадией, характером поражения, распространенностью патологического процесса. Если раньше метастазы в легких практически не удаляли, то сегодня такие операции делают, однако и не так редко. К сожалению, при множественных метастатических узлах повышаются риски осложнений, например, массивные кровотечения, тяжелая травматизация тканей, сложная реабилитация. Радикальное лечение возможно лишь в некоторых случаях:
- первичный очаг не локализован в легких;
- отсутствие прочих метастазов от имеющихся вторичных очагов;
- 1-2 узла в легочной ткани;
- отсутствие выраженной прогрессии патологического процесса (оценивается годовая динамика).
Операция проводится только при нормальном самочувствии больного, если отсутствуют тяжелые полиорганные патологии, есть лишь незначительные признаки онкологической болезни. Организм пациента должен вынести не только вмешательство, но и реабилитационный период.
Преимущественный выбор в лечении рака и метастаз в легких – курсы химиотерапии наряду с гормонотерапией, если первичные очаги локализованы в гормонозависимых органах. Под воздействием медикаментозных препаратов происходит уничтожение патологически измененных клеток, опухоль разрушается. Благоприятный прогноз определяется временем вмешательства. Если лечение начато вовремя, а течение рака умеренное или медленное, то химиотерапия приносит вполне приличные результаты.
Лучевая терапия при метастазах в легких не несет особого положительного результата, вне зависимости от количества вторичных очагов.
Реабилитационный период после операции включает интенсивный курс химиотерапии. Если медикаментозное лечение выбрано в качестве монотерапии, реабилитация направлена не только на восстановление, но и на предупреждение серьезных органных осложнений: нарушения функции почек, печени, сердечно-сосудистой системы.
К сожалению, появление метастазов относится к терминальной стадии рака, поэтому говорить о полном выздоровлении практически не приходится. Даже при успешном удалении вторичных очагов сохраняется риск появления новых метастаз, возникновения той же самой клинической ситуации.
Если опухоль неоперабельная, а химиотерапия не принесла результатов, вызвала ухудшение самочувствия больного, переходят на паллиативное лечение, которое подразумевает купирование болевого синдрома наркотическими анальгетиками, улучшение качества жизни больных, санаторно-курортное пребывание в специальных стационарах для тяжелых онкологических больных.
Прогноз
Сколько живут при метастазах в легких? Прогноз при метастазах в легких и первичной раковой опухоли очень вариативен. При множественных метастазах без лечения можно прожить 10-12 месяцев, при адекватной терапии – до 5 лет. При регулярном лечении, дисциплинированности больного в плане исследований и динамических наблюдений пятилетняя выживаемость составляет 65%. Прогноз улучшается, если первичный очаг значительной удален от органов дыхания, а метастазы единичны.
Злокачественная опухоль и ее метастазы – серьезное клиническое состояние, требующее обязательного наблюдения. Рак легких и метастазы сегодня не приговор, методы лечения постоянно совершенствуются. Прогноз на жизнь зависит от множественных факторов, включая возраст, пол, текущий анамнез и особенности течения патологического процесса.